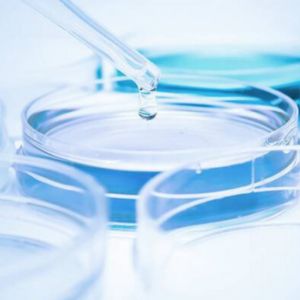
Retinol Skin Renewing

Acest produs face parte din campania Elite si beneficiaza de TRANSPORT GRATUIT* la Pachetomat
*vezi detaliiImagine cu titlu de prezentare. Ambalajul, culoarea sau inscriptiile pot varia.
Brand: CERAVE
Cod produs: 3337875899543
Tip: Produs dermato-cosmetic
Vandut de: Bebetei Investments Group SRL
Livrare până la 4 zile lucrătoare
Livrare până la 4 zile lucrătoare
Livrare până la 4 zile lucrătoare
La noi, prețul afișat este valabil atât pentru comenzile online cât și pentru toate locațiile noastre.
Dacă intervin abateri de la această regulă, sunt erori pentru care ne cerem scuze și vă rugăm să ni le semnalați.
Dezvoltat împreună cu medicii dermatologi, Serumul cu Retinol Skin Renewing CeraVe hidratează, în timp ce reduce aspectul liniilor fine și al ridurilor de la nivelul pielii și ajută la restabilirea barierei cutanate.

Beneficii:
.jpg)

Ajută la restabilirea barierei pielii.
Reduce aspectul liniilor fine și al ridurilor

Ajută la menținerea hidratării naturale a pielii
Mod de utilizare:
Aplicați uniform serumul în fiecare seară pe ten și gât. Precauții de utilizare: Evitați contactul cu ochii și buzele
Ingrediente:
Aqua/Water, Glycerin, Caprylic/Capric Triglyceride, Potassium Cetyl Phosphate, Hydrogenated Palm Glycerides, Polysorbate 20, Dimethicone, PEG-40 Stearate, Potassium Phosphate, Ceramide NP, Ceramide AP, Ceramide EOP, Carbomer, Niacinamide, Triethanolamine, Cetearyl Alcohol, Behentrimonium Methosulfate, Triethyl Citrate, Cichorium Intybus Root Extract/Chicory Root Extract, Lecithin, Retinol, Sodium Lauroyl Lactylate, Sodium Hyaluronate, Cholesterol, Phenoxyethanol, Alcohol, Tocopherol, Hydroxyethylcellulose, Caprylyl Methicone, Hydroxyacetophenone, Citric Acid, Caprylyl Glycol, Trisodium Ethylenediamine Disuccinate, Pentylene Glycol, Xanthan Gum, Phytosphingosine, Butyrospermum Parkii Butter/Shea Butter, Ethylhexylglycerin, Benzoic Acid.
Prezentare:
30 ml
Dezvoltat împreună cu medicii dermatologi, Serumul cu Retinol Skin Renewing CeraVe hidratează, în timp ce reduce aspectul liniilor fine și al ridurilor de la nivelul pielii și ajută la restabilirea barierei cutanate. Cu retinol încapsulat, 3 ceramide esențiale și acid hialuronic. Potrivit pentru tenul sensibil.
Aplicati uniform serumul in fiecare seara pe ten si gat.
3 ceramide esentiale - ajuta la restabilirea barierei pielii.
Retinol incapsulat - reduce aspectul liniilor fine si ridurilor.
Acid hialuronic - ajuta la mentinerea hidratarii naturale a pielii.
Evitati contactul cu ochii si buzele. In cazul contactului, clatiti cu apa din abundenta.
Daca apare o senzatie de disconfort in timpul primei aplicari, diminuati frecventa aplicarii pana cand pielea se adapteaza.
Evitati expunerea excesiva la soare si aplicati o crema de protectie solara in fiecare dimineata.
Nu utilizati pe pielea deteriorata sau iritata.
Contine Vitamina A. Luati in considerare aportul zilnic inainte de utilizare.
Aqua/Water, Glycerin, Caprylic/Capric Triglyceride, Potassium Cetyl Phosphate, Hydrogenated Palm Glycerides, Polysorbate 20, Dimethicone, PEG-40 Stearate, Potassium Phosphate, Ceramide NP, Ceramide AP, Ceramide EOP, Carbomer, Niacinamide, Triethanolamine, Cetearyl Alcohol, Behentrimonium Methosulfate, Triethyl Citrate, Cichorium Intybus Root Extract/Chicory Root Extract, Lecithin, Retinol, Sodium Lauroyl Lactylate, Sodium Hyaluronate, Cholesterol, Phenoxyethanol, Alcohol, Tocopherol, Hydroxyethylcellulose, Caprylyl Methicone, Hydroxyacetophenone, Citric Acid, Caprylyl Glycol, Trisodium Ethylenediamine Disuccinate, Pentylene Glycol, Xanthan Gum, Phytosphingosine, Butyrospermum Parkii Butter/Shea Butter, Ethylhexylglycerin, Benzoic Acid.
30 ml
| Specificatie | Valori |
|---|---|
| Brand | Cerave |
| Stoc | În stoc |
| Disponibil in magazinele Bebe Tei | Biharia, Sun Plaza, Brasov, Rebreanu, Craiova, Vitan, Vivo Constanta, Pitesti, Plaza Romania, Ploiesti, Cluj-Napoca |
| Info produs | Dermato cosmetic, Eligibil ELITE |
| Cod produs | 3337875899543 |
| Tip produs | Produs dermato-cosmetic |